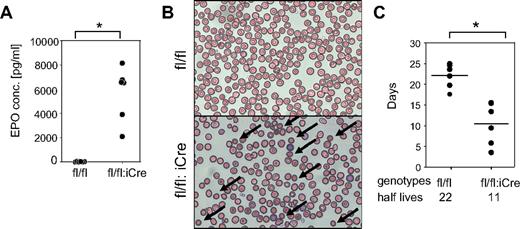
Figure 3. RHAUfl/fl:vav-iCre mice develop hemolytic anemia. (A) Increased erythropoietin level in blood plasma of RHAUfl/fl:vav-iCre mice. *P < .05; n = 6 for each group. (B) Blood smear examination shows the presence of spherocytes (arrows) in RHAUfl/fl:vav-iCre mice; (top) RHAUfl/fl; (bottom) RHAUfl/fl:vav-iCre. (C) Shortened lifespan of erythrocytes lacking RHAU. The half-lives of erythrocytes were determined by chasing biotinylated cells in vivo. Each dot represents the half-life value of erythrocytes from an individual mouse. The horizontal lines represent the average values, which are indicated at the bottom of the graph. *P < .05; n = 6 for RHAUfl/fl and n = 5 for RHAUfl/fl:vav-iCre.

Abstract
The DEAH helicase RHAU (alias DHX36, G4R1) is the only helicase shown to have G-quadruplex (G4)–RNA resolvase activity and the major source of G4-DNA resolvase activity. Previous report showed RHAU mRNA expression to be elevated in human lymphoid and CD34+ BM cells, suggesting a potential role in hematopoiesis. Here, we generated a conditional knockout of the RHAU gene in mice. Germ line deletion of RHAU led to embryonic lethality. We then targeted the RHAU gene specifically in the hematopoiesis system, using a Cre-inducible system in which an optimized variant of Cre recombinase was expressed under the control of the Vav1 promoter. RHAU deletion in hematopoietic system caused hemolytic anemia and differentiation defect at the proerythroblast stage. The partial differentiation block of proerythroblasts was because of a proliferation defect. Transcriptome analysis of RHAU knockout proerythroblasts showed that a statistically significant portion of the deregulated genes contain G4 motifs in their promoters. This suggests that RHAU may play a role in the regulation of gene expression that relies on its G4 resolvase activity.
Introduction
Correct folding of RNA is critical for proper cellular functions such as transcription, splicing, RNA turnover, and translation initiation.1-3 These processes involve dynamic changes in covalent modification and spatial rearrangement between RNA and proteins. RNA chaperones, such as RNA helicases, facilitate the dynamic structural changes and regulate transitional states of RNA. Encoded by all living organisms, RNA helicases use energy released by NTP hydrolysis for unwinding RNA or remodeling protein–RNA complexes.4,5 Down-regulation or overexpression of some mammalian helicases or their homologs has evidenced their critical roles in growth and development.6-12 Deregulated expression of certain RNA helicases may also be linked to some diseases.13 However, the biologic activities of only a small number of mammalian RNA helicases have been studied so far.
RHAU (alias DHX36, G4R1), am RNA helicase of the DEAH family, is evolutionary conserved with true orthologs in almost all animal species.14 Human and mouse RHAU, NP 065916.2 and NP 082412.2, respectively, share ≤ 92% similarity of amino acid sequence. The guanine quadruplex (G4) resolvase activity on both DNA and RNA substrates of RHAU is a unique characteristic among RNA helicases.14,15 RHAU was originally identified as a regulator of urokinase-type plasminogen activator mRNA stability, binding to an AU-rich element in the 3′ untranslated region,16 but further investigation suggested other functions. RHAU protein was found to be localized mainly in the nucleus, colocalized at nuclear speckles with the DEAD-box helicases p68 and p72, suggesting a nuclear function.17 In line with this, RNAi-mediated knockdown of RHAU in HeLa cells was shown to affect the transcription of various genes both positively and negatively.17 Recent reports have shown that RHAU knockdown in plasmacytoid dendritic cells interferes with viral DNA infection responses18 and that RHAU also interacts with the cytoplasmic domain of Toll-like receptor 1,19 suggesting roles in innate immunity. Thus, RHAU appears to be a multifunction protein.
Because RHAU is found only in metazoans, its function(s) appeared later in evolution. Global gene expression analysis of RHAU in humans and mice has shown ubiquitous expression, with prominently elevated levels in lymphoid and BM cells,20 suggesting a role in hematopoiesis. To address the role of RHAU in development and in hematopoiesis, we produced germ line as well as hematopoietic cell–specific conditional knockout mice. Here, we show that conventional RHAU ablation causes embryonic lethality without affecting implantation and that its ablation of this helicase in the hematopoietic system affects development of several lineages, suggesting critical and specific roles for RHAU in these processes.
Methods
Generation of RHAU-targeted mice
The detailed procedures are described in supplemental Methods (available on the Blood Web site; see the Supplemental Materials link at the top of the online article). Briefly, we used standard procedures for transgenic mouse generation and targeted the exon 8 of the mouse DHX36 gene. Different conditional RHAU knockout mice were obtained by crossing to Meox2Cre, Mx-Cre, or Vav-iCre (optimized variant of Cre recombinase) lines. Animal experimentation was performed according to regulations effective in the canton of Basel-Stadt, Switzerland. Standard PCR and Western blot analysis were used for detection of RHAU knockout in tissues.
Whole blood counting
Blood was collected by tail bleeding into EDTA-coated BD Microtainer K2E tubes (BD PharMingen). Complete blood cell counting was performed in an Advia 120 Hematology Analyzer, and the results were analyzed by Multispecies Version 2.3.01-MS software (Bayer).
FACS analysis
Eight-week-old mice were used for all analysis. BM cells from femur and tibia were flushed with 3% FCS PBS (FACS buffer). Splenocytes and thymocytes were collected from whole spleen and thymus by pressing with a plunger through a 2-mL syringe into the FACS buffer. Spleen and BM cells were treated with red blood cell (RBC) lysis buffer for 7 minutes on ice and stained for different cell markers. A list of the reagents, target cells, and suppliers is given in supplemental Table 1.
Quantitation of erythropoietin plasma concentrations
Blood samples were collected by tail bleeding into 1.5-mL centrifuge tubes and allowed to clot for 16 hours at 4°C. Clotted blood was centrifuged at 2000g for 20 minutes. The supernatant fluid was diluted with Calibrator Diluent RD6Z provided together with the Mouse/Rat Epo (erythropoietin) Immunoassay kit (R&D Systems). The concentration of Epo in the samples was determined according to the instructions provided by the manufacture.
BM transplantation
BM cells were collected from femora and tibiae of 8-week-old mice. Cells (3 × 106) in 200 μL of HBSS were injected into the tail vein of lethally irradiated (1100 cGy in 2 doses separated by 3 hours) 7- to 10-week-old mice. C57BL/6SJL-PtprcaPep3b/BoyJ (B6.CD45.1) mice and green fluorescent protein (GFP)–expressing C57BL/6-Tg(UBC-GFP)30Scha/J [Tg(GFP)] (UBC-GFP) mice were used as recipients. Five weeks after BM transplantation, recipient mice were treated with polyinosine-polycytidylic acid (polyI:C). Chimerism of recipient mice was analyzed with anti-CD45.1–allophycocyanin (eBioscience) and anti-CD45.2 peridinin chlorophyll protein complex with cyanine 5.5 (BD PharMingen). Efficiency of RHAU knockout was ∼ 98% in BM and ∼ 47% in the spleen as determined by genotyping of individual clones formed in a colony-forming assay.21
BrdU incorporation assay
Each 8-week-old mouse was injected with 1 mg of BrdU in sterile solution. Eighteen hours after injection, BM cells were isolated and depleted of RBCs as for FACS analysis. One million cells were stained with anti-CD71–PE and anti–Ter-119–allophycocyanin Abs. Preparation of cells for BrdU detection was achieved with the use of the APC BrdU Flow Kit (BD PharMingen), according to the manufacturer's instructions.
CFSE staining of splenocytes and cell cycle kinetic analysis
Freshly isolated, RBC-depleted splenocytes were stained with anti-CD71–PE and anti–Ter-119–allophycocyanin Abs. Dead cells were excluded with 4′-6′-diamidine-2-phenylindole staining. Sorted proerythroblasts (ProEs; n = 20 000) were incubated with 1μM CFSE (Sigma-Aldrich) in PBS with 5% FCS at room temperature for 5 minutes. Then cells were washed with IMDM 15% FSC twice and seeded in fibronectin-coated wells (1 μg/cm2). Cells were cultured in 1 mL of IMDM containing 15% FCS, 1% BSA, 200 μg/mL holo-transferrin (Sigma-Aldrich), 10 μg/mL insulin (Sigma-Aldrich), 2mM l-glutamine, 0.4mM 2-mercaptoethanol (Gibco), and 2 U/mL human recombinant Epo (Sigma-Aldrich) for 72 hours before submitted for FACS analysis.22
Results
Targeting of the RHAU gene in mice
To delete the RHAU gene, we designed a targeting vector in which 2 Cre recombinase recognition (loxP) sites flanked exon 8 of the gene as well as a neomycin-resistant gene cassette inserted downstream of exon 8, which itself was flanked by 2 Flippase recognition target sites. Deletion of this exon introduces a frameshift to yield a prematured termination codon that leads to the total decay of the message through a nonsense-mediated mRNA decay mechanism.23 In the targeted allele, recombination with CRE deletes both exon 8 and the neomycin cassette, whereas FLP deletes only the neomycin cassette (supplemental Figure 1A). The linearized vector was transfected into embryonic stem cells, and correctly targeted cells (clones 2 and 42) with the genotype RHAUfl,neo/+ were detected by Southern blot analysis (supplemental Figure 1B). PCR analysis of these clones with the use of the primer pairs mod4/7 and mod2/8 yielded the predicted products (supplemental Figure 1C). Corrected targeted embryonic stem cells were submitted for chimeric mice generation. Primer pair KO3fw and KO3rev was used to distinguish RHAU+/+, RHAUfl,neo/+ alleles (supplemental Figure 1D). RHAUΔ/+ mice were derived by crossing RHAUfl,neo/+ with Meox-CRE mice, whereas RHAUfl/fl mice were obtained by first deleting the neo cassette from RHAUfl,neo/+ by crossing with ROSA26Flpo mice and then interbreeding with RHAUfl/+ mice as described in supplemental Methods, Experimental procedures.
Conventional RHAU knockout in mouse is embryonically lethal
Inbreeding of RHAUΔ/+ mice produced either RHAU+/+ or RHAUΔ/+ but no RHAUΔ/Δ offspring, indicating that RHAU ablation causes embryonic lethality. RHAUΔ/+ pups had a wild-type phenotype and developed normally. RHAUΔ/+ × RHAUΔ/+ crosses yielded degenerated fetuses at 11.5 days postcoitus (dpc), but genotyping was not possible because of poor recovery of material. At 8.5 dpc, DNA samples of degenerated fetuses were recovered and genotyped as RHAUΔ/Δ (supplemental Table 2 top). Structural differences between RHAUΔ/Δ and RHAUΔ/+ embryos were observed already at 7.5 dpc (supplemental Figure 2). However, at 6.5 dpc, structurally degenerate embryos were not observed, although some embryos were RHAUΔ/Δ (supplemental Table 2). Therefore, RHAUΔ/Δ embryos died at ∼ 7.0 dpc.
RHAU gene ablation in the hematopoietic system results in anemia
Given the early embryo lethality of RHAUΔ/Δ embryos, the role of RHAU in the hematopoietic system was studied by conditional knockout in vav-iCre mice. These mice show specific Cre recombinase activity in all hematopoietic lineages, beginning with the hematopoietic stem cells.24 In contrast to RHAUΔ/Δ pups, RHAUfl/fl:vav-iCre pups were viable with normal Mendelian ratio (RHAUfl/fl:vav-iCre/RHAUfl/fl is 1:1 ratio; χ2 value = 32; P < .01). RHAUfl/fl:vav-iCre pups were born with pale color, suggesting that the mutant mice are anemic (Figure 1A). Western blot analysis confirmed the efficient and specific ablation of the RHAU protein in RHAUfl/fl:vav-iCre mice in hematopoietic organs (Figure 1B). The RHAU exon 8 was shown to be deleted in Lin−IL7Ra−c-Kit+Sca-1+Thy1.1+ HSCs that had undergone FACS (Figure 1B). Adult RHAUfl/fl:vav-iCre mice developed splenomegaly and hepatomegaly (Figure 1C-D). Accordingly, the livers and kidneys of RHAUfl/fl:vav-iCre mice were relatively pale in color. In addition, RHAUfl/fl:vav-iCre mice developed thymic hypoplasia (Figure 1C-D). However, RHAU ablation had no effect on body or kidney weight (Figure 1C-D). Furthermore, in standard H&E staining (supplemental Methods), distinct structures of red and white pulp were absent in spleens (Figure 1E), and in contrast there were no obvious structural changes in the thymus (Figure 1E).
Phenotypes of RHAUfl/fl:vav-iCre mice. (A) Anemic appearance of newborn RHAUfl/fl:vav-iCre mice with specific RHAU ablation in the hematopoietic system. (B left) Western blot (WB) analysis of the efficiency of RHAU ablation in hematopoietic organs. (B right) Genotype analysis of HSCs by PCR. HSCs were sorted by FACS as described in “FACS analysis” (supplemental Table 1). The genotypes of mice are (1), RHAUfl/fl; (2), RHAUfl/+:vav-iCre; and (3), RHAUfl/fl:vav-iCre. (C) Liver, spleen, thymus, and kidney of RHAUfl/fl:vav-iCre and control RHAUfl/fl mice. (D) Total body mass and relative body mass of each organ from RHAUfl/fl:vav-iCre and RHAUfl/fl mice. Each dot represents the relative body mass expressed as the ratio of organ weight to total body weight. *P < .05; n = 16. (E) H&E staining of spleen and thymus from RHAUfl/fl and RHAUfl/fl:vav-iCre mice (magnification, ×4; bar, 500 μm). RHAUfl/fl and RHAUfl/fl:vav-iCre are presented as fl/fl and fl/fl:iCre in figures, respectively.
Phenotypes of RHAUfl/fl:vav-iCre mice. (A) Anemic appearance of newborn RHAUfl/fl:vav-iCre mice with specific RHAU ablation in the hematopoietic system. (B left) Western blot (WB) analysis of the efficiency of RHAU ablation in hematopoietic organs. (B right) Genotype analysis of HSCs by PCR. HSCs were sorted by FACS as described in “FACS analysis” (supplemental Table 1). The genotypes of mice are (1), RHAUfl/fl; (2), RHAUfl/+:vav-iCre; and (3), RHAUfl/fl:vav-iCre. (C) Liver, spleen, thymus, and kidney of RHAUfl/fl:vav-iCre and control RHAUfl/fl mice. (D) Total body mass and relative body mass of each organ from RHAUfl/fl:vav-iCre and RHAUfl/fl mice. Each dot represents the relative body mass expressed as the ratio of organ weight to total body weight. *P < .05; n = 16. (E) H&E staining of spleen and thymus from RHAUfl/fl and RHAUfl/fl:vav-iCre mice (magnification, ×4; bar, 500 μm). RHAUfl/fl and RHAUfl/fl:vav-iCre are presented as fl/fl and fl/fl:iCre in figures, respectively.
RHAU ablation causes decrease in RBCs
To verify the anemic appearance observed in RHAU-ablated mice, peripheral blood samples from 8-week-old RHAUfl/fl, RHAUfl/+:vav-iCre, and RHAUfl/fl:vav-iCre mice were analyzed. As expected, RHAUfl/fl:vav-iCre mice exhibited anemia that was evidenced by typical symptoms, such as lowered RBC count, decreased hemoglobin (Hb) level, and increased mean corpuscular volume (MCV), among others (Figure 2A; supplemental Table 3 group A). Because these experiments did not distinguish whether the anemic phenotype in RHAUfl/+:vav-iCre was because of an intrinsic or extrinsic effect, we generated an IFN-inducible RHAU knockout mouse model to address this issue by BM transplantation experiments.
RHAU ablation leads to anemia. (A) Dot plots of total RBC counts, Hb values, and MCV from total blood count analysis from RHAUfl/fl and RHAUfl/fl:vav-iCre mice. (B) Dot plots of RBC, Hb, and MCV data from RHAUfl/fl and RHAUfl/fl:vav-iCre mice and recipient mice of BM transplantation assays. Genotypes of mice are shown in the table. The data points are presented in supplemental Table 3. *P < .05; n ≥ 3. ● represents control conditions; and ○, RHAU-ablated condition.
RHAU ablation leads to anemia. (A) Dot plots of total RBC counts, Hb values, and MCV from total blood count analysis from RHAUfl/fl and RHAUfl/fl:vav-iCre mice. (B) Dot plots of RBC, Hb, and MCV data from RHAUfl/fl and RHAUfl/fl:vav-iCre mice and recipient mice of BM transplantation assays. Genotypes of mice are shown in the table. The data points are presented in supplemental Table 3. *P < .05; n ≥ 3. ● represents control conditions; and ○, RHAU-ablated condition.
Anemic phenotype of RHAUfl/fl:vav-iCre mice is an intrinsic effect
In addition, 2 BM transplantation experiments were performed to test whether the phenotypes observed in RHAUfl/fl:vav-iCre mice were cell autonomous and independent of the hematopoietic microenvironment. First, RHAUfl/+;vav-iCre and RHAUfl/fl:vav-iCre mice were used as donors and UBC-GFP and BL6.CD45.1 mice were used as recipients (see “BM transplantation”). Blood was examined every 2-3 weeks after the fifth week of transplantation (supplemental Table 3 groups B1 and B2). Two of the 3 UBC-GFP mice transplanted with BM cells from RHAUfl/fl:vav-iCre mice died 6 weeks after transplantation; thus, only results for the fifth week were obtained for group B1. BM transplantations were repeated with the use of RHAUfl/fl;MxCre mice and sibling RHAUfl/fl mice as donors and UBC-GFP and BL6.CD45.1 as recipients. IFN induction of MxCre recombinase activity was achieved by injecting mice with polyI:C after transplantation.21 Complete blood analysis was performed periodically (Figure 2B; supplemental Table 3 groups A, B, C1, and C2).
When we compared blood of control and targeted mice, we found that mice responded to RHAU ablation consistently in 11 parameters (supplemental Table 3). First, all RHAU-ablated mice were anemic with low RBC count and lowered Hb and hematocrit counts. In addition, anemic mice developed reticulocytosis, as shown by an increase in the proportion of reticulocytes and increased MCV (Figure 2B; supplemental Table 3). All mice had reductions in platelets and white blood cell (WBC) counts, the latter being mainly because of reduced lymphocytes (Figure 2B; supplemental Table 3). Because the phenotypes of mice transplanted with RHAU-ablated BM cells and RHAUfl/fl:vav-iCre mice were similar, the effects of RHAU ablation in RHAUfl/fl:vav-iCre mice appeared to be cell autonomous, and these mice were used for further studies of the effects of RHAU ablation on hematopoiesis.
Hemolytic anemia and ineffective erythropoiesis in RHAUfl/fl:vav-iCre mice
RHAU-ablated mice developed anemia accompanied by elevation of the reticulocyte ratios (supplemental Table 3). Such reticulocytosis is induced by Epo signaling, and an increase in Epo is commonly observed in the blood of anemic animals, whereby it compensates for the reduction in erythrocytes.25 The plasma Epo level was 800-fold higher in RHAUfl/fl:vav-iCre mice than in control RHAUfl/fl mice (Figure 3A); thus, the reticulocytosis observed here was a secondary effect of RHAU ablation. We also observed spherocytes in the blood of RHAUfl/fl:vav-iCre mice (Figure 3B) and found that the half-life of erythrocytes in RHAUfl/fl:vav-iCre mice was reduced from 20 days to < 10 days (Figure 3C). Furthermore, RHAUfl/fl:vav-iCre mice developed enlarged spleens (Figure 1). These symptoms indicate hemolytic anemia.26
RHAUfl/fl:vav-iCre mice develop hemolytic anemia. (A) Increased erythropoietin level in blood plasma of RHAUfl/fl:vav-iCre mice. *P < .05; n = 6 for each group. (B) Blood smear examination shows the presence of spherocytes (arrows) in RHAUfl/fl:vav-iCre mice; (top) RHAUfl/fl; (bottom) RHAUfl/fl:vav-iCre. (C) Shortened lifespan of erythrocytes lacking RHAU. The half-lives of erythrocytes were determined by chasing biotinylated cells in vivo. Each dot represents the half-life value of erythrocytes from an individual mouse. The horizontal lines represent the average values, which are indicated at the bottom of the graph. *P < .05; n = 6 for RHAUfl/fl and n = 5 for RHAUfl/fl:vav-iCre.
RHAUfl/fl:vav-iCre mice develop hemolytic anemia. (A) Increased erythropoietin level in blood plasma of RHAUfl/fl:vav-iCre mice. *P < .05; n = 6 for each group. (B) Blood smear examination shows the presence of spherocytes (arrows) in RHAUfl/fl:vav-iCre mice; (top) RHAUfl/fl; (bottom) RHAUfl/fl:vav-iCre. (C) Shortened lifespan of erythrocytes lacking RHAU. The half-lives of erythrocytes were determined by chasing biotinylated cells in vivo. Each dot represents the half-life value of erythrocytes from an individual mouse. The horizontal lines represent the average values, which are indicated at the bottom of the graph. *P < .05; n = 6 for RHAUfl/fl and n = 5 for RHAUfl/fl:vav-iCre.
Although the shortened half-life of erythrocytes could explain the decreased RBC counts in RHAUfl/fl:vav-iCre mice, the total reticulocyte count was not significantly enhanced in these mice, which strikingly developed an 800-fold elevated Epo level (supplemental Table 3). Because an elevated Epo level is expected to promote erythropoiesis through increasing the progenitor population, the response to Epo of RHAUfl/fl:vav-iCre mice might be impaired.27 We therefore examined the different subsets of erythroblasts that correspond to different stages of maturation. ProE is the earliest progenitor that is completely committed to erythropoiesis and undergoes maturation through the following stages: basophilic erythroblast, late basophilic erythroblast, polychromatic erythroblast, orthochromatic erythroblast, and, finally, reticulocyte that is enucleated and released into the blood stream.28 Erythroblast subpopulations can be well defined by FACS according to cell size and the expression of Ter-119 and CD71 (Figure 4A).28 Ter119med CD71hi cells correspond to the ProE fraction. The high Ter-119 subpopulation was further analyzed by CD71 and forward scatter parameter to identify 3 erythroblast subpopulations, Ery.A, Ery.B, and Ery.C. Previous reports determined that basophilic erythroblasts contribute to Ery.A, late basophilic and polychromatic erythroblasts contribute to Ery.B, whereas orthochromatic erythroblasts and reticulocytes contribute to Ery.C.28 Examination of erythroblasts in BM of RHAUfl/fl:vav-iCre mice found dramatic increases in the proportions of ProE and Ery.A fractions (Figure 4B); in contrast, Ery.B and Ery.C decreased (Figure 4B). In the spleen, the ProE and Ery.A fractions increased, whereas Ery.B did not change and Ery.C decreased (Figure 4B). Thus, the increase in the proportions of ProE and Ery.A in both BM and spleen indicated a partial differentiation block at an early stage of erythropoiesis. With respect to total erythroblast counts, BM and spleen responded differently (Figure 4C). In the BM, total erythroblasts decreased, whereby ProE increased and Ery.B and Ery.C decreased significantly. In contrast, total erythroblasts increased dramatically 4.7-fold in spleen, with all subgroups contributing to the increase.
Differential effects of RHAU ablation on erythroid cell differentiation in the BM and spleen. (A-B) The different developmental stages were identified by FACS with the use of Ter-119 and CD71 markers together with the forward scatter (FSC) parameter.28 Ter119+ cells are classified into the following 4 subgroups: ProE (Ter119med CD71hi), Ery.A (Ter119hiCD71hiFSChi), Ery.B (Ter119hiCD71hiFSClow), and Ery.C (Ter119hiCD71lowFSClow). The mean proportions of each subgroup ± SEs (n = 4) are shown beside the boxes in the dot plots. (C) Effect of RHAU ablation on total numbers of erythroblasts in the BM and spleen. Cell numbers of the 4 subgroups are indicated in the bars by different colors, denoting, from the top, Pro.E, Ery.A, Ery.B, and Ery.C. *P < .05; n = 4.
Differential effects of RHAU ablation on erythroid cell differentiation in the BM and spleen. (A-B) The different developmental stages were identified by FACS with the use of Ter-119 and CD71 markers together with the forward scatter (FSC) parameter.28 Ter119+ cells are classified into the following 4 subgroups: ProE (Ter119med CD71hi), Ery.A (Ter119hiCD71hiFSChi), Ery.B (Ter119hiCD71hiFSClow), and Ery.C (Ter119hiCD71lowFSClow). The mean proportions of each subgroup ± SEs (n = 4) are shown beside the boxes in the dot plots. (C) Effect of RHAU ablation on total numbers of erythroblasts in the BM and spleen. Cell numbers of the 4 subgroups are indicated in the bars by different colors, denoting, from the top, Pro.E, Ery.A, Ery.B, and Ery.C. *P < .05; n = 4.
Ineffective differentiation of progenitors and stem cells in RHAUfl/fl:vav-iCre mice
In response to elevated Epo levels in RHAU-ablated mice, ProE cells increased in number by 3.6- and 74-fold in BM and spleen, respectively (Figure 5A). However, RHAU ablation resulted in a progressive decline in the fold change of Ery.A, Eyr.B, and Ery.C cells compared with the control in both BM and spleen (Figure 5A). Therefore, RHAU ablation led to progressive differentiation defects in erythropoiesis that are most prominent at the ProE stage.
Loss of RHAU leads to progressive reduction in the population expansion ability of hematopoietic cells. (A) The numbers of ProE, Ery.A, Ery.B, and Ery.C cells in the BM and spleen are shown. The number at the top of each bar graph indicates the fold increase/decrease after RHAU ablation. *P < .05; n = 4. The order of cell differentiation in the erythrocytic lineage is indicated: ProE → Ery.A → Ery.B →Ery.C. (B) Effect of RHAU ablation on the number of stem cells. The mean numbers ± SEs of different cell types are shown as bar charts. The number at the top of each bar graph indicates the fold change after RHAU ablation. Arrows indicate the path of early hematopoiesis: LT-HSC → ST-HSC → LMPP or → CMP. *P < .05; n = 6. (C) The progressive reduction of RHAU-ablated hematopoietic cells in population expansion ability was shown in competitive repopulation assays. Two different combinations of BM cells, (i) UBC-GFP and RHAUfl/fl in a 1:10 ratio or (ii) UBC-GFP and RHAUfl/fl:MxCre in a 1:10 ratio, were transplanted into BL6.CD45.1 mice. The recipient mice were divided into 3 groups. Group 1 recipient mice were transplanted with UBC-GFP and RHAUfl/fl cells (n = 3), group 2 recipient mice were transplanted with UBC-GFP and RHAUfl/fl:MxCre cells (n = 4), and group 3 recipient mice were transplanted with UBC-GFP and RHAUfl/fl:MxCre cells (n = 4). Mice from groups 1 and 2 were treated with polyI:C 5 weeks after BM transplantation and mice in group 3 were kept untreated; *P < .05.
Loss of RHAU leads to progressive reduction in the population expansion ability of hematopoietic cells. (A) The numbers of ProE, Ery.A, Ery.B, and Ery.C cells in the BM and spleen are shown. The number at the top of each bar graph indicates the fold increase/decrease after RHAU ablation. *P < .05; n = 4. The order of cell differentiation in the erythrocytic lineage is indicated: ProE → Ery.A → Ery.B →Ery.C. (B) Effect of RHAU ablation on the number of stem cells. The mean numbers ± SEs of different cell types are shown as bar charts. The number at the top of each bar graph indicates the fold change after RHAU ablation. Arrows indicate the path of early hematopoiesis: LT-HSC → ST-HSC → LMPP or → CMP. *P < .05; n = 6. (C) The progressive reduction of RHAU-ablated hematopoietic cells in population expansion ability was shown in competitive repopulation assays. Two different combinations of BM cells, (i) UBC-GFP and RHAUfl/fl in a 1:10 ratio or (ii) UBC-GFP and RHAUfl/fl:MxCre in a 1:10 ratio, were transplanted into BL6.CD45.1 mice. The recipient mice were divided into 3 groups. Group 1 recipient mice were transplanted with UBC-GFP and RHAUfl/fl cells (n = 3), group 2 recipient mice were transplanted with UBC-GFP and RHAUfl/fl:MxCre cells (n = 4), and group 3 recipient mice were transplanted with UBC-GFP and RHAUfl/fl:MxCre cells (n = 4). Mice from groups 1 and 2 were treated with polyI:C 5 weeks after BM transplantation and mice in group 3 were kept untreated; *P < .05.
Hematopoiesis is a stepwise process, and the long-term repopulating HSCs (LT-HSCs) give rise to all different hematopoietic cells through different stages of maturation.29 Because RHAU ablation led to differentiation defects at the ProE stage, we speculated whether lack of RHAU would also affect other progenitors in the hematopoietic system. To examine this we performed FACS analysis of BM using Abs directed against markers specific for early hematopoietic differentiation stages, including megakaryocyte/erythroid (MEPs), granulocyte/macrophage progenitors (GMPs), common myeloid progenitors (CMPs), lymphoid primed multipotent progenitors (LMPPs), short-term repopulating HSCs (ST-HSCs), and LT-HSCs. Indeed, a similar differentiation defect was also seen in the other hematopoietic progenitors in the BM. Figure 6A-B shows the gating of CMPs, MEPs, GMPs, LMPPs, ST-HSCs, and LT-HSCs. According to the percentage of the gated cells, the absolute numbers of different populations were calculated and presented as bar charts. RHAU ablation had no effect on CMP total cell number, either in the BM or spleen, but caused a significant decrease in GMP cell number in the BM and an increase in the MEP cell number in spleen (Figure 6B). For earlier progenitors, both LT-HSC and ST-HSC numbers increased, but LMPPs did not change compared with the control mice (Figure 6D).
Effects of RHAU ablation on progenitors and stem cells. (A) FACS analysis of MEP, GMP, and CMP cells in BM and spleen. Lin−CD127Ra/IL-7Ra− living cells were gated and analyzed for c-kit+ and Sca-1− populations (LK). The LK subgroup was further gated for CD34 and CD16/32 (FcγR). CMPs, GMPs, and MEPs were identified as FcγRlowCD34+, FcγRhighCD34+, and FcγRlowCD34−, respectively. The mean proportions ± SEs of CMP, GMP, and MEP cells are indicated in the graphs. *P < .05; n = 6. (B) Absolute numbers of progenitor cells in the BM and spleen; *P < .05; n = 6. (C) FACS analysis of LT-HST, ST-HST and LMPP cells in BM. Lineage-negative BM cells were first gated to obtain IL-7Ra−Sca-1+c-Kit+ cells, which were further gated into 2 populations: Thy1.1lo/+ and Thy1.1−. These were further probed for VCAM-1 and Flt3/CD135 expression. LT-HSCs, ST-HSCs, and LMPPs were defined as Thy1.1+VCAM-1+Flt3−, Thy1.1+VCAM-1+Flt3+, and Thy1.1−VCAM-1−flt3+, respectively. The mean proportions ± SEs of different populations are indicated in the graphs; *P < .05; n = 6. (D) Effect of RHAU ablation on the numbers of stem cells. The mean numbers ± SEs of each cell type are shown as bar charts; *P < .05; n = 6.
Effects of RHAU ablation on progenitors and stem cells. (A) FACS analysis of MEP, GMP, and CMP cells in BM and spleen. Lin−CD127Ra/IL-7Ra− living cells were gated and analyzed for c-kit+ and Sca-1− populations (LK). The LK subgroup was further gated for CD34 and CD16/32 (FcγR). CMPs, GMPs, and MEPs were identified as FcγRlowCD34+, FcγRhighCD34+, and FcγRlowCD34−, respectively. The mean proportions ± SEs of CMP, GMP, and MEP cells are indicated in the graphs. *P < .05; n = 6. (B) Absolute numbers of progenitor cells in the BM and spleen; *P < .05; n = 6. (C) FACS analysis of LT-HST, ST-HST and LMPP cells in BM. Lineage-negative BM cells were first gated to obtain IL-7Ra−Sca-1+c-Kit+ cells, which were further gated into 2 populations: Thy1.1lo/+ and Thy1.1−. These were further probed for VCAM-1 and Flt3/CD135 expression. LT-HSCs, ST-HSCs, and LMPPs were defined as Thy1.1+VCAM-1+Flt3−, Thy1.1+VCAM-1+Flt3+, and Thy1.1−VCAM-1−flt3+, respectively. The mean proportions ± SEs of different populations are indicated in the graphs; *P < .05; n = 6. (D) Effect of RHAU ablation on the numbers of stem cells. The mean numbers ± SEs of each cell type are shown as bar charts; *P < .05; n = 6.
Along the differentiation path, LT-HSCs differentiate into ST-HSCs, and ST-HSCs differentiate into MPPs that different into either LMPPs or CMPs.30 Here, we observed a progressive decrease in the proportions of LT-HSCs, ST-HSCs, and LMPPs in RHAU-ablated mice compared with the control mice (Figure 5B). At the beginning, the RHAUfl/fl:vav-iCre mice developed 5.8-fold more LT-HSCs than control mice. However, this increase in number disappears in the later stages of differentiation and finally showed no difference to the control mice at the LMPP and CMP stages (Figure 5B). This suggests that RHAU ablation impairs population expansion and reduces the differentiation potential of HSCs. Competitive BM transplantation experiments were performed to verify that the reduction in population expansion and differentiation potential of HSCs were caused by RHAU ablation in these cells. Lethally irradiated BL6.CD45.1 mice were used as recipients for mixtures of BM cells composed either of UBC-GFP and RHAUfl/fl or UBC-GFP and RHAUfl/fl;MxCre, both in ratios of 1:10. The mice were then divided into 3 groups. Group 1 consisted of recipients transplanted with UBC-GFP and RHAUfl/fl cells and treated with polyI:C, group 2 consisted of recipients transplanted with UBC-GFP and RHAUfl/fl;MxCre cells and treated with poly I:C, and group 3 consisted of recipients transplanted with UBC-GFP and RHAUfl/fl;MxCre cells without polyI:C treatment. CD45.2+GFP+ and CD45.2+GFP− leukocytes were considered to be derived from UBC-GFP and RHAUfl/fl (or RHAUfl/fl;MxCre) donors, respectively. Before polyI:C treatment, > 90% of cells were derived from donors (CD45.2+), indicating the transplantation was effective. Of the CD45.2+ leukocytes, the majority (> 80%) were initially GFP− in groups 1, 2, and 3 (Figure 5C). After polyI:C treatments, RHAU was ablated in the RHAUfl/fl;MxCre cells, and the proportion of CD45.2+GFP/CD45.2+GFP− cells was monitored periodically (see “BM transplantation”). As expected, RHAU-ablated hematopoietic cells showed a progressive decline in number (Figure 5C), which was significant after 3 weeks of treatment. Because of the longer half-life of leukocytes than that of erythrocytes, the effect of RHAU ablation on the reduction of cell population became observable only a few weeks later in leukocytes. These results suggested that RHAU-expressing leukocytes and erythrocytes outgrow RHAU-ablated cells and support the conclusion that the reductions in population expansion and differentiation potential were caused specifically by RHAU ablation and were cell autonomous.
Ineffective erythropoiesis of RHAUfl/fl:vav-iCre mice is associated with a cell cycle defect
Reduced proliferation and enhanced cell death can lead to differentiation block in erythropoiesis.31 To test whether the defects of differentiation of ProEs is because of a decreased rate of cell division, we monitored in vivo proliferation rates of ProEs in BM by injecting the DNA analog BrdU in mice (see “BrdU incorporation assay”). At 18 hours after injection, RBC-depleted BM cells were treated according to the protocol from the manufacturer, and BrdU+ cells were analyzed from the gated ProE (Ter119med CD71hi) population. As shown in Figure 7A, most of control RHAUfl/fl ProEs were undergoing proliferation as the peak for the BrdU+ population higher than that of the BrdU− population. In contrast, the proportion of BrdU+ and BrdU− populations were similar in RHAU-ablated ProEs (Figure 7A). The quantification in Figure 7B shows that the percentage of BrdU+ ProEs in RHAUfl/fl:vaviCre mice was significantly lower than in control mice. This implies a reduced proliferation rate in RHAU-ablated ProEs. We further used CFSE to track the cell division rate in vitro in purified ProEs from spleen. CFSE enters cells and diffuses throughout the cytoplasm. On cell division, the CFSE is equally split between the daughter cells, resulting in decreased fluorescence signals; this allows monitoring of the number of divisions undergone by a cell.27 ProEs from BM cells were sorted as Ter119med CD71hi population and were immediately stained with CSFE, after which time they were grown for 3 days in the presence of Epo. From the histograms (Figure 7C), the RHAU-ablated ProEs gave a higher CFSE signal compared with the wild-type ProEs. To test whether RHAU ablation leads to enhanced cell death of ProEs, freshly harvested ProEs were stained with annexin V to monitor apoptotic activity. However, RHAU-ablated ProE cells did not show a higher apoptotic rate than wild-type ProEs (Figure 7D). Together, these data show that the partial differentiation block at the ProE stage in RHAU-ablated cells is because of decreased cell cycle kinetics and is independent of apoptosis.
Decreased erythropoiesis potential in RHAUfl/fl:vav-iCremice is because of decreased proliferation ability of ProEs. (A) Histogram showing the BrdU signals in ProEs. Most of the ProEs were BrdU+ in RHAUfl/fl mice. In contrast, most of the ProEs are BrdU− in mice lacking RHAU. (B) Percentage of BrdU+ cells from RHAUfl/fl and RHAUfl/fl:vav-iCre mice; *P < .05; n = 3. (C) Histogram showing CFSE signals. RHAU-ablated ProEs retained higher CFSE signals than wild-type ProEs after 3 days of culture. Freshly isolated ProEs were stained with CFSE on day 0 and cultured for 3 days in medium supplied with Epo to sustain proliferation. The wild-type ProEs showed the highest peak at a lower CFSE signal intensity, whereas the RHAU-ablated ProEs showed the highest peak at the highest CFSE signal. (D) Histogram showing annexin V binding activity of Ter-119+ erythroblasts isolated from the spleen.
Decreased erythropoiesis potential in RHAUfl/fl:vav-iCremice is because of decreased proliferation ability of ProEs. (A) Histogram showing the BrdU signals in ProEs. Most of the ProEs were BrdU+ in RHAUfl/fl mice. In contrast, most of the ProEs are BrdU− in mice lacking RHAU. (B) Percentage of BrdU+ cells from RHAUfl/fl and RHAUfl/fl:vav-iCre mice; *P < .05; n = 3. (C) Histogram showing CFSE signals. RHAU-ablated ProEs retained higher CFSE signals than wild-type ProEs after 3 days of culture. Freshly isolated ProEs were stained with CFSE on day 0 and cultured for 3 days in medium supplied with Epo to sustain proliferation. The wild-type ProEs showed the highest peak at a lower CFSE signal intensity, whereas the RHAU-ablated ProEs showed the highest peak at the highest CFSE signal. (D) Histogram showing annexin V binding activity of Ter-119+ erythroblasts isolated from the spleen.
Preferential deregulation of genes carrying a G4 motif in their promoter in RHAU-ablated ProEs
Given the reduced expansion of the cell population observed in the erythrocyte lineage, we examined the effect of RHAU ablation on gene expression in ProEs, an erythroblast stage associated with extensive population expansion. Transcriptomes of wild-type and RHAU knockout ProEs were obtained by microarray analysis, and a list of deregulated genes was generated with a cutoff of 2-fold change and a P value of < .01. Because RHAU is a DNA/RNA-G4 resolvase, we examined whether there is a correlation between the deregulated genes in RHAU-ablated ProEs and the ratio of genes whose promoters contain G4 motifs. According to the Greglist database,32 30% of the total expressed genes in the ProEs contain putative G4 motifs in the promoter regions (Figure 3; supplemental Table 5). Among the RHAU-regulated genes, the percentage of genes that contain G4 motif in their promoter increased to 37%. The enrichment of G4 motif that contain promoters is statistically significant, with a P value of .03 (supplemental Figure 3; supplemental Tables 4-5). Because RHAU ablation affected the expansion of ProEs, we were particularly interested in genes that regulated the cell cycle. When the deregulated genes were grouped according to the cell cycle function and the cellular localization of their products by Ingenuity Pathway Analysis (Ingenuity System), the enrichment of genes carrying the G4 motif promoter became more obvious. From the 220 deregulated genes found, 32 are involved in cell cycle regulation, and of these 15 encode nuclear-localized proteins. G4 motifs are present in 11 (73%) of the 15 nuclear protein-encoding genes (supplemental Figure 3; supplemental Table 5). The enrichment in G4 motif promoter genes is not observable in other gene groups; for example, genes that are involved in cell cycle regulation but not functioning in the nucleus or that are regulating cell death and functioning in the cell nucleus (supplemental Table 5).
Discussion
RHAU is required for early embryogenesis
The analysis of embryo viability showed that RHAU is essential for gastrulation because in the absence of RHAU embryos died at the gastrulation stage. Interestingly, embryo degeneration and developmental defects were also observed after ablation of another DEAH helicase in mice.9 Thus, these results identify a possible general role of DEAH helicases in mouse embryogenesis, possibly in connection with the regulation of factors important for organogenesis.33,34
RNA helicases in hematopoiesis
So far, only one member of the DEAH family has been implicated in hematopoiesis. Ubiquitously expressed DHX32 is specifically down-regulated in acute lymphoblastic leukemia,35 but a causal role for this helicase in leukemia development has not yet been addressed. In the present work, we have demonstrated that RHAU plays an essential role in hematopoiesis in a stage- and lineage-specific manner. As hematopoiesis involves many discrete steps regulated at multiple levels in which various RNA metabolic activities occur, it would not be surprising to find that further RNA helicases are involved in this process.
Loss of RHAU causes anemia, reduction in blood platelet count, and leukopenia
Decreases in RBC, platelet, and WBC counts were consistently observed in RHAU-ablated mice. Among the WBCs, neutrophils and lymphocytes declined the most in RHAU-ablated mice. However, the effects of RHAU-ablation on basophils and eosinophils could not be determined unambiguously because the counts were not consistent between the animals with and without BM transplantations. The cause of the discrepancy in basophils and eosinophils between the 2 systems might be because of the different housing environments of the mice; RHAUfl/fl:vav-iCre mice and their control siblings were housed in open cages, whereas the mice that received a transplant were housed in sterilized filter-top cages. Thus, the increase in basophils and eosinophils in the RHAUfl/fl:vav-iCre mice might be a consequence of exposure to airborne pathogens.
The anemic phenotype of the RHAUfl/fl:vav-iCre mice was largely because of the shortened half-life of erythrocytes. In addition, spherocytosis indicated that the enhanced phagocytic activity of RBCs in the spleen could be the primary cause of the hemolytic anemia in the RHAUfl/fl:vav-iCre mice.36 Therefore, RHAUfl/fl:vav-iCre mice could provide a valuable tool for studying the mechanism of hemolytic anemia associated with splenomegaly.
Lineage-specific effect of RHAU ablation on cell differentiation
In the competitive BM transplantation experiments, outgrowth of RHAU-expressing hematopoietic cells over RHAU-ablated cells was observed in the recipient mice. Therefore, RHAU appeared to be essential in the development of both myeloid and lymphoid lineages. This defect can be accounted for by the inefficient population propagation of stem cells and progenitors before lineage commitment. However, analysis of individual lineages showed that RHAU is differentially required for the development of different lineages. In the erythroid lineage, RHAU ablation hindered progression of erythroblast cells at the ProE-to-Ery.A stage. Nevertheless, RHAU-ablated erythroblasts still developed to mature RBCs. Beside the erythroid lineage, the lymphoid lineage also requires RHAU for its development because the peripheral lymphocyte counts were dramatically decreased in RHAU-ablated mice. Furthermore, although the numbers of differentiated lymphoid cells and erythrocytes was low, the number of LT-HSCs was enhanced in the absence of RHAU. We speculate that the increase in LT-HSCs might be a response to insufficiently functioning hematopoietic stem cells. This might be similar to the phenomenon of increased ProEs in response to elevated Epo in anemic RHAUfl/fl:Vav-iCre mice.
Possible involvement of the G4 motif in RHAU-dependent gene regulation in ProE cells
G4-DNA and G4-RNA are highly stable structures formed in guanine-rich regions of DNA or RNA under physiologic conditions.37,38 G4-DNA/RNAs are 4-stranded, thermodynamically highly stable, nucleic acid structures with numerous varieties.39 G4 motifs appear throughout the genome, across species, and in a functional orientated manner. This suggests that G4 structures are involved in diverse biologic functions.39 G4 motifs are present in the promoter regions of many proliferation-associated genes, telomeres, repetitive DNA regions, and also in immunoglobulin heavy chain genes.39 It was suggested that complex secondary structures at the promoter may act as transcription repressors. Removing the G4 structure by substituting the critical guanine residues with adenines was found to enhance basal transcription levels several fold.40 Similarly, G4 motifs are also present in untranslated regions of some mRNAs and diminish their translation efficiency.41 Depletion of RHAU protein in HeLa cells, either by treating the cell extracts with a specific monoclonal Ab or by expressing RHAU-specific shRNA in the cell, causes a dramatic reduction in G4-DNA– and G4-RNA–resolving activities in the cell extracts.15,42 Previous reports had further shown that increasing quantities of purified recombinant RHAU are directly proportional to the resolution activity of tetramolecular and unimolecular G4 DNA in vitro in an ATP-dependent manner.15,42,43 These results argue for a critical role of RHAU in G4-mediated cellular functions.15,42 The observation that RHAU can bind to and resolve both DNA and RNA and also can shuttle between nucleus and cytoplasm suggests that it could regulate gene expression at both the DNA and RNA levels.17 Although it was shown that RHAU binds and resolves G4-RNA with a higher efficiency than G4-DNA, this does not necessarily imply that RHAU mainly acts on RNA.43 Indeed, other RNA helicases that are shuttling between nucleus and cytoplasm, such as RHA, p68, and p72, are also involved in both RNA and DNA metabolisms.44 In fact, the localization and the composition of the ribonucleoprotein complexes define the functions and mechanisms of helicases rather than the helicase by itself. Accordingly, as shown in this study, decreased proliferation and altered transcriptomes in RHAU-ablated ProE cells suggests that G4 motifs in promoter regions play a role in the regulation of genes involved in cell cycle regulation and whose products are localized in the nucleus. The grouping of genes deregulated after RHAU ablation correlated with enrichment in G4-containing promoters. Thus, through a common mechanism that involved G4, RHAU may cooperatively regulate specific groups of genes at the transcription level. It is not yet clear which mechanisms may be involved in RHAU-mediated regulation of embryogenesis and hematopoiesis because RHAU binds to and resolves both G4-DNA and G4-RNA structures.42 Analysis of the DNA and RNA sequences bound by RHAU by ChIP-seq and RNA immunoprecipitation will provide important insights on how RHAU regulates gene expression.
FANCJ (homolog of DOG-1 in Caenorhabditis elegans), BLM, and WRN are 3 other DNA helicases that also bind and resolve G4-DNA.43,44 These helicases are essential for genome stability. Deficiency of any one of these helicases is linked to various diseases, including premature aging and cancers.39 Genetic knockout of these helicases have been achieved previously. BLM-null mice are embryonically lethal45 and, although WRN-null mice are normal, WRN-null fibroblasts undergo premature senescence.46 Comparative Genomic Hybridization experiments have shown that deficiency of FANCJ or DOG-1 leads to deletion of sequences that are close to G4 motifs.47 Furthermore, a recent study showed that FANCJ, BLM, and WRN are essential for epigenetic stability of DNA sequences associated with G4 motifs.48 Although RHAU can bind the G4 motif, it has never been found associated with these well-studied helicases. Therefore, it will be important to further investigate whether RHAU regulates gene expression and cell proliferation through similar pathways as FANCJ, WRN, and BLM or through a novel pathway that involves G4 motifs.
In conclusion, we identified RHAU as a DEAH helicase critical for mouse early embryogenesis and have shown for the first time that a DEAH helicase is essential for hematopoiesis in mammals.
The online version of this article contains a data supplement.
The publication costs of this article were defrayed in part by page charge payment. Therefore, and solely to indicate this fact, this article is hereby marked “advertisement” in accordance with 18 USC section 1734.
Acknowledgments
The authors thank Patrick Kopp and Jean-François Spetz of the Friedrich Miescher Institute Transgenic Mice Production Facility for the generation of RHAU floxed mice, and Simon Lattmann for critical reading of the manuscript.
This work was supported by the Novartis Research Foundation.
Authorship
Contribution: J.C.L., S.P., D.P, and H.K. designed and performed the research and analyzed data; R.C.S., P.M., and Y.N. designed the research and contributed vital new reagents; and J.C.L., P.M., and Y.N. wrote the paper.
Conflict-of-interest disclosure: The authors declare no competing financial interests.
Correspondence: Patrick Matthias, Friedrich Miescher Institute for Biomedical Research, Maulbeerstrasse 66, 4058 Basel, Switzerland; e-mail: patrick.matthias@fmi.ch.